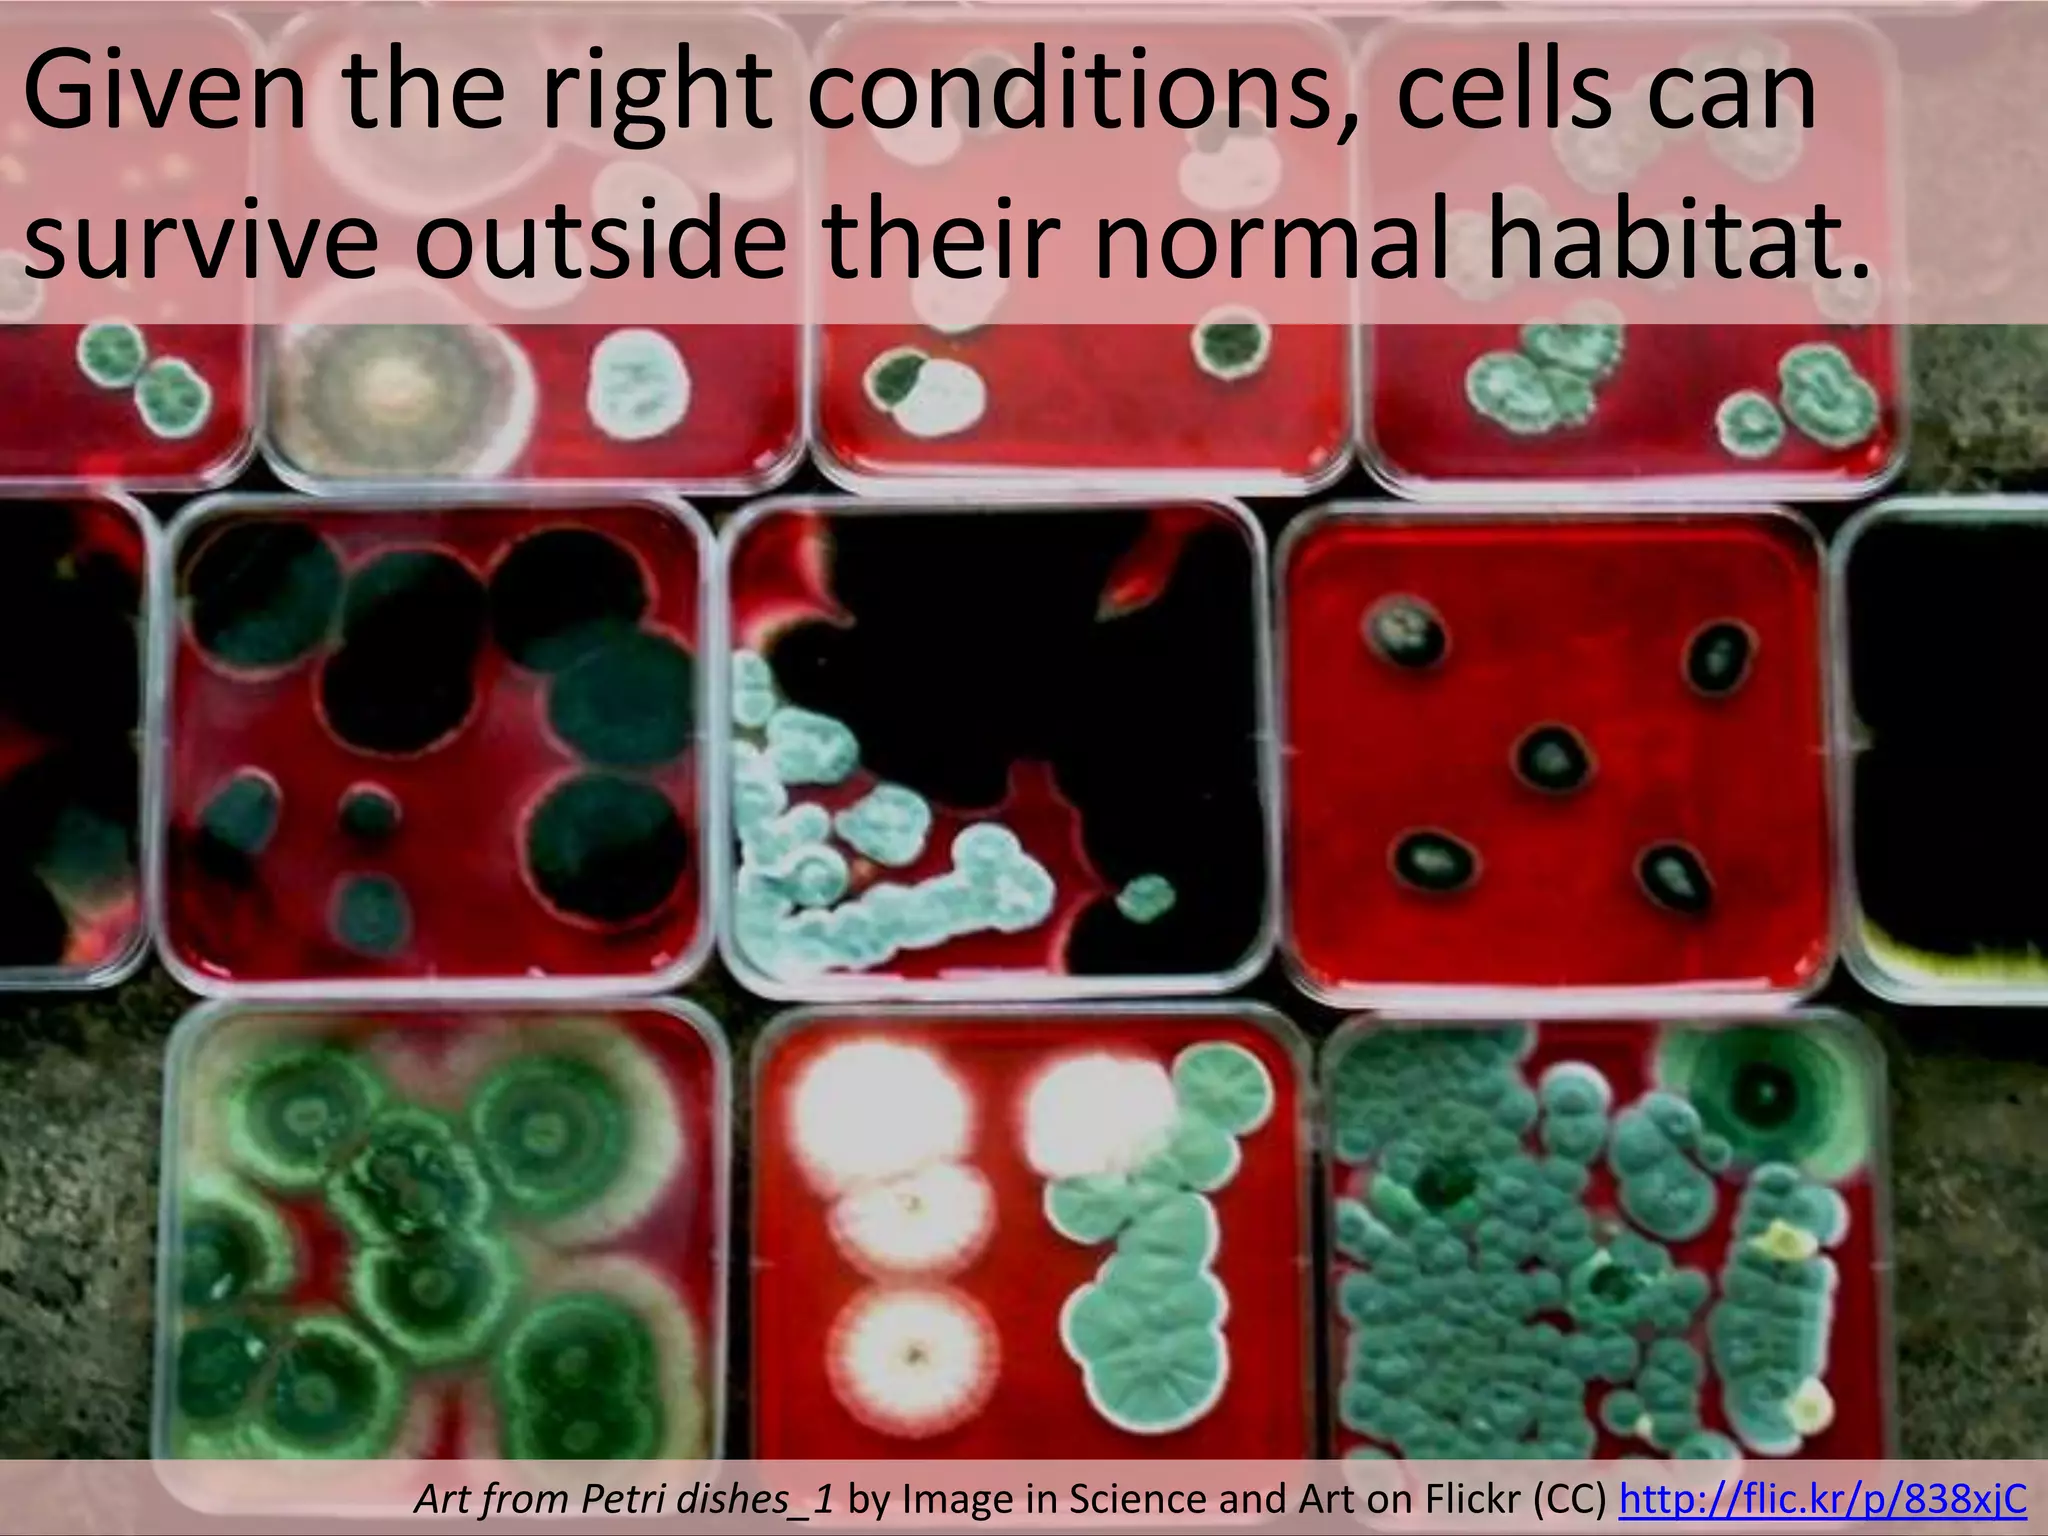
Given the right conditions, cells can
survive outside their normal habitat.

Art from Petri dishes_1 by Image in Science and Art on Flickr (CC) http://flic.kr/p/838xjC

The document discusses cell theory and provides a brief history and overview of key concepts. It states that all living things are made of cells, which are the smallest units of life. Unicellular organisms consist of single cells, while multicellular organisms have specialized cell types. Cells come only from existing cells through division.

![Stem Cells retain the capacity to divide and can
differentiate along divergent pathways.
By Fwfu at en.wikibooks [Public domain], from Wikimedia Commons
http://commons.wikimedia.org/wiki/File%3AStemcelldifferentiaion.jpg](https://image.slidesharecdn.com/21-cell-theory-1229337563033670-1/75/Cell-Theory-68-2048.jpg)






